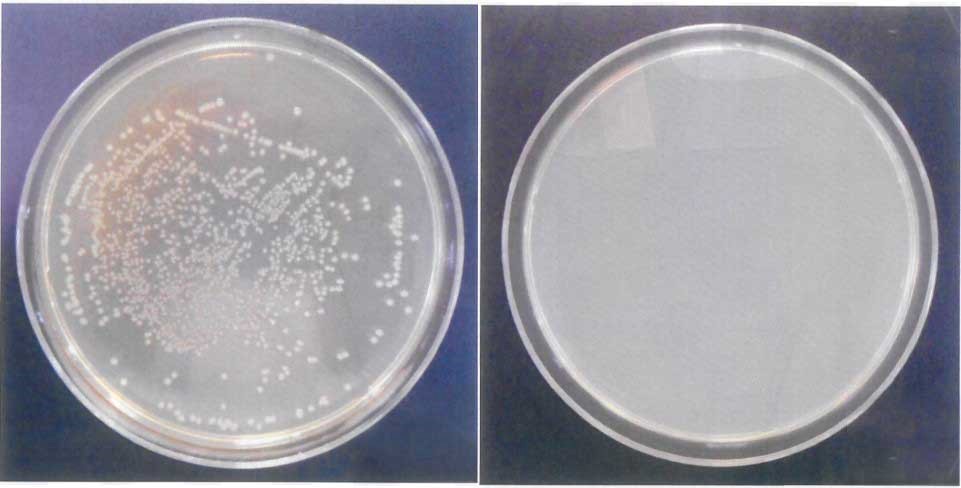
▲아이엘사이언스의 UVC  LED 조사 전후 대장균 분포 변화 (사진=회사제공)

스마트 광학솔루션 기업 아이엘사이언스가 자체 개발한 UVC(자외선 C) LED(발광다이오드)로 99.9%의 뛰어난 살균력을 입증했다고 23일 밝혔다.
해당 시험은 국가공인 시험검사기관인 한국건설생활환경시험연구원을 통해 진행됐으며 아이엘사이언스의 275nm UVC LED를 60cm 거리에서 10분 동안 조사(照射)한 결과 대장균이 99.9% 살균된 것으로 확인됐다.
단파장 자외선 종류인 UVC는 바이러스 및 세균을 강력하게 살균하는 효과를 갖고 있는 것으로 알려졌다. 국제전기전자공학회(IEEE)가 발간하는 ‘스펙트럼’지는, 파장이 짧은 자외선이 인체에 해를 주지 않으면서도 공기 중의 코로나19와 같은 바이러스를 효과적으로 제거할 수 있다는 미국 컬럼비아대 연구진의 연구 결과를 게재한 바도 있다.
코로나19 바이러스 팬데믹이 장기화 하면서 위생·살균 제품에 대한 수요가 폭발적으로 증가하고 있는 가운데, 아이엘사이언스의 UVC LED는 실생활에 적용 가능하다는 점에서 최근 건설회사를 비롯해 다양한 업계의 관심을 받고 있다고 회사 측은 전했다.
특히 정기적인 살균이 중요한 화장실, 주방, 신발장 같은 개인 생활공간은 물론, 많은 사람들이 함께 이용하는 다중 커뮤니티 시설에도 공간 특성에 따른 맞춤형 IoT(사물인터넷) 살균 솔루션을 제공할 수 있다는 장점이 있다.
앞서 아이엘사이언스는 UVE LED가 장착된 IoT 살균 스마트화장실을 관계사 아이엘커누스와 공동 개발해 특허를 출원했다. 화장실 이용자 재실 여부를 센서가 자동 감지해 부재 시에만 약 1분간 UVC LED를 작동시켜 좌변기에 잔류한 바이러스를 살균하는 방식이다.
아이엘사이언스 송성근 대표는 “코로나19 등 각종 바이러스, 세균에 대한 UVC의 살균 효과는 해외 유명 학술지를 통해 누차 입증됐다”며 “이번에 살균력을 검증받은 자사의 UVC LED를 적극적으로 활용해 모두의 건강한 삶을 위한 다양한 살균 응용제품 및 솔루션을 선보일 예정”이라고 말했다.



